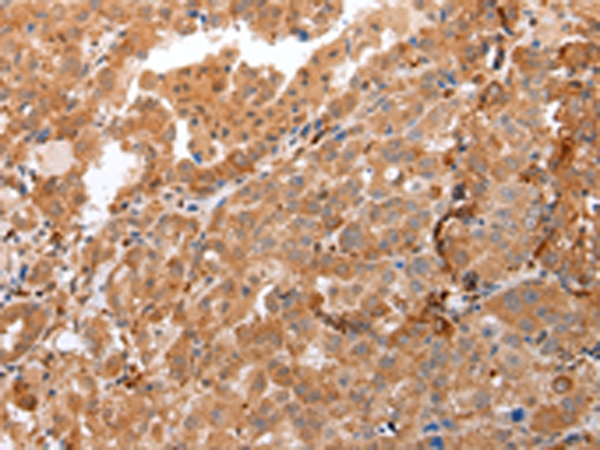
一抗

中文名稱: 兔抗DEFB4A多克隆抗體
|
Background: |
Defensins form a family of microbicidal and cytotoxic peptides made by neutrophils. Members of the defensin family are highly similar in protein sequence. This gene encodes defensin, beta 4, an antibiotic peptide which is locally regulated by inflammation. |
|
Applications: |
ELISA, IHC |
|
Name of antibody: |
DEFB4A |
|
Immunogen: |
Synthetic peptide of human DEFB4A |
|
Full name: |
defensin, beta 4A |
|
Synonyms: |
BD-2; SAP1; DEFB2; DEFB4; HBD-2; DEFB-2; DEFB102 |
|
SwissProt: |
O15263 |
|
ELISA Recommended dilution: |
2000-5000 |
|
IHC positive control: |
Human ovarian cancer and Human thyroid cancer |
|
IHC Recommend dilution: |
25-100 |

 購物車
購物車 幫助
幫助
 021-54845833/15800441009
021-54845833/15800441009